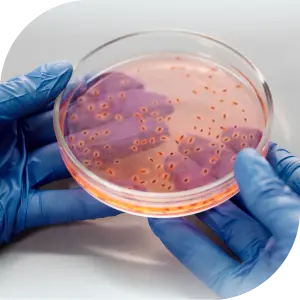

Vetom Moldova
Distribuitor oficial Vetom în Moldova. Produse cu microorganisme probiotice pentru sănătatea plantelor și a animalelor.
COMPANIE ȘTIINȚIFICĂ ȘI DE PRODUCȚIE
RESEARCH CENTER
Compania științifică și de producție „Research Center” a fost înființată la 6 septembrie 1993 pe baza unuia dintre laboratoarele NPO „Vector” o instituție științifică de vârf a industriei microbiologice din URSS.

Suprafață de producție
mai mult de 30.000 metri pătrați

Producție proprie
linii și echipamente de producție avansate

Bună Practică de Fabricație
Certificat

Laborator de testare acreditat
pentru control biotehnologic
Cercetări
în domeniul biotehnologiei

Peste 50
de teze de doctorat și 6 dizertații doctorale

